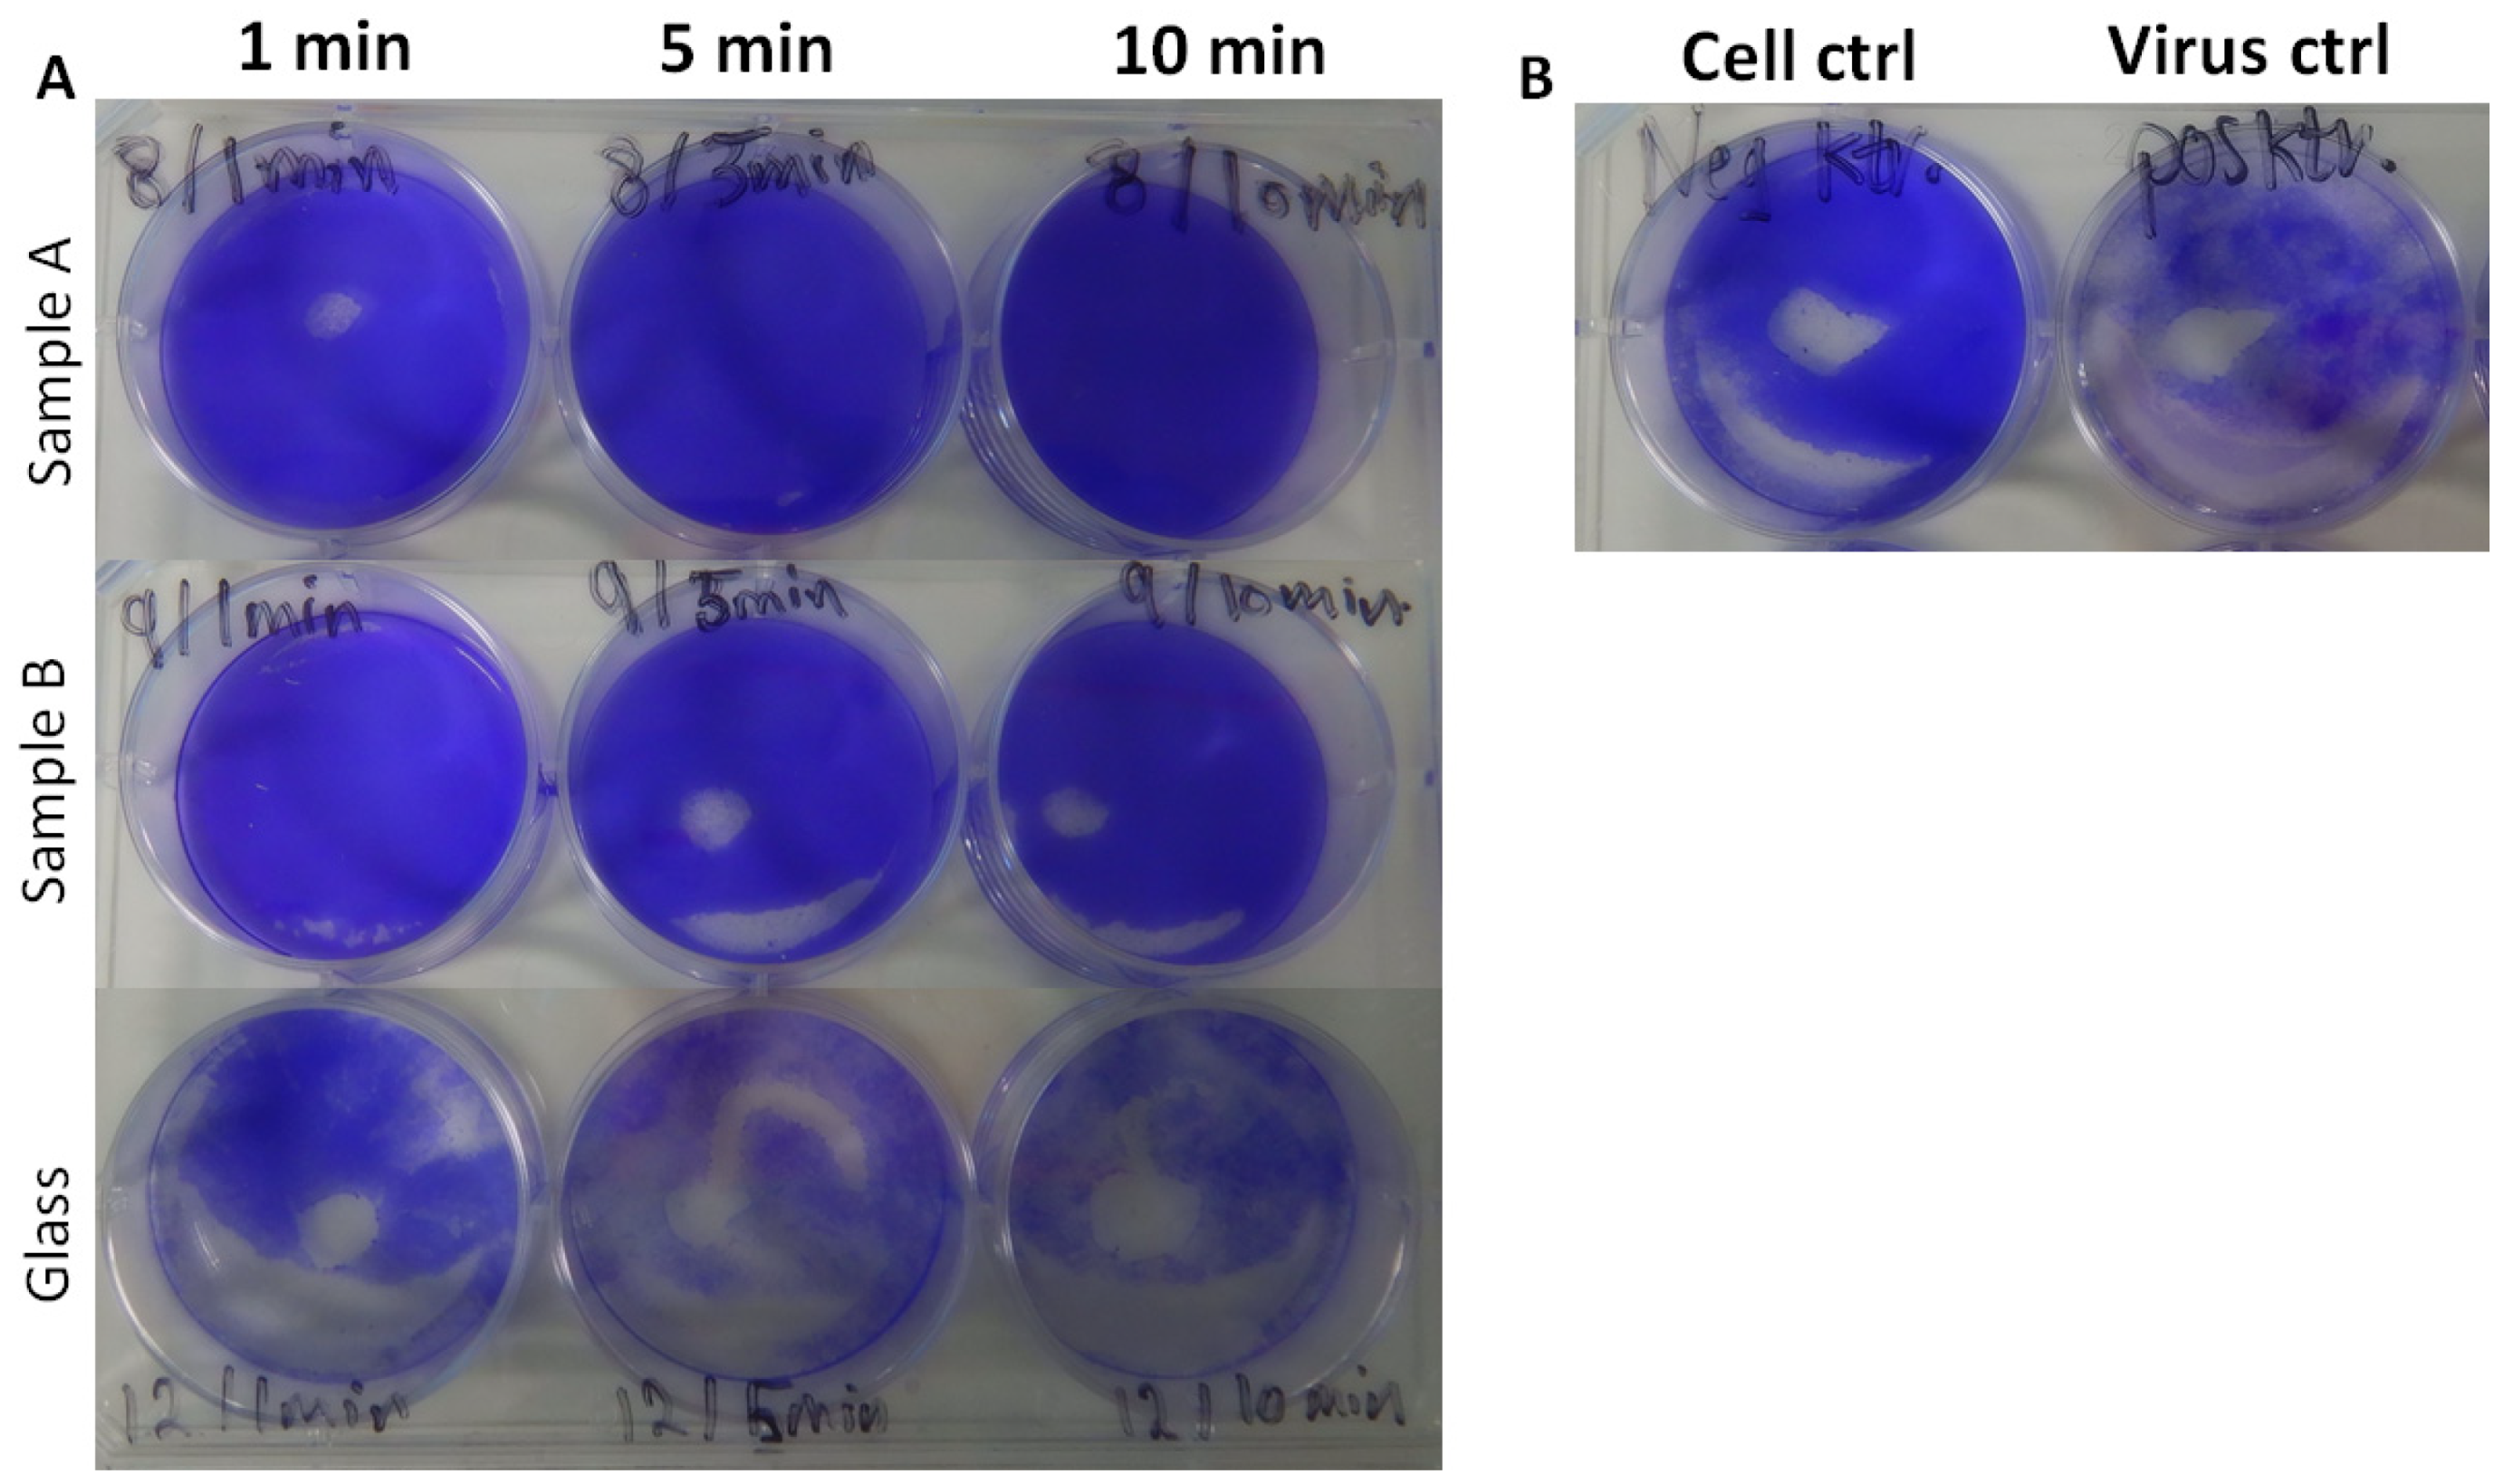
Nanomaterials 12 01037 g006

Inhibition of SARS-CoV-2 Alpha Variant and Murine Noroviruses on Copper-Silver Nanocomposite Surfaces
Abstract
:1. Introduction
2. Materials and Methods
2.1. Copper –Silver Nanocomposite Surfaces and Their Characterization
2.2. SARS-CoV-2 and Norovirus Strains, Cell Cultures, and Surface Exposure Experiments
2.3. Cytopathic Effects (CPEs) by the Alpha Variant and Microscopy of MNV-Infected Cells
2.4. RT-PCR of the Tested Alpha Variant Samples
3. Results and Discussion
3.1. Copper–Silver Nanocomposite Surfaces and Their Characterization
3.2. Surface Inhibition of the Alpha Variant and MNV
4. Conclusions
Supplementary Materials
Author Contributions
Funding
Institutional Review Board Statement
Informed Consent Statement
Data Availability Statement
Acknowledgments
Conflicts of Interest
References
- WHO. COVID-19 Weekly Epidemiological Update, 77th ed.; World Health Organization: Geneva, Switzerland, 2022; pp. 1–15. [Google Scholar]
- Rakowska, P.D.; Tiddia, M.; Faruqui, N.; Bankier, C.; Pei, Y.; Pollard, A.J.; Zhang, J.; Gilmore, I.S. Antiviral Surfaces and Coatings and Their Mechanisms of Action. Commun. Mater. 2021, 2, 53. [Google Scholar] [CrossRef]
- Cardemil, C.V.; Parashar, U.D.; Hall, A.J. Norovirus Infection in Older Adults: Epidemiology, Risk Factors, and Opportunities for Prevention and Control. Infect. Dis. Clin. N. Am. 2017, 31, 839–870. [Google Scholar] [CrossRef] [PubMed]
- Lopman, B.; Gastañaduy, P.; Park, G.W.; Hall, A.J.; Parashar, U.D.; Vinjé, J. Environmental Transmission of Norovirus Gastroenteritis. Curr. Opin. Virol. 2012, 2, 96–102. [Google Scholar] [CrossRef]
- Ahmed, S.M.; Hall, A.J.; Robinson, A.E.; Verhoef, L.; Premkumar, P.; Parashar, U.D.; Koopmans, M.; Lopman, B.A. Global Prevalence of Norovirus in Cases of Gastroenteritis: A Systematic Review and Meta-Analysis. Lancet Infect. Dis. 2014, 14, 725–730. [Google Scholar] [CrossRef] [Green Version]
- Lazarus, J.V.; Ratzan, S.C.; Palayew, A.; Gostin, L.O.; Larson, H.J.; Rabin, K.; Kimball, S.; El-Mohandes, A. A Global Survey of Potential Acceptance of a COVID-19 Vaccine. Nat. Med. 2021, 27, 225–228. [Google Scholar] [CrossRef]
- World Health Organiztion. Ten Threats to Global Health in 2019. Available online: https://www.who.int/news-room/spotlight/ten-threats-to-global-health-in-2019 (accessed on 15 February 2022).
- Behzadinasab, S.; Chin, A.; Hosseini, M.; Poon, L.; Ducker, W.A. A Surface Coating That Rapidly Inactivates SARS-CoV-2. ACS Appl. Mater. Interfaces 2020, 12, 34723–34727. [Google Scholar] [CrossRef]
- Mlcochova, P.; Chadha, A.; Hesselhoj, T.; Fraternali, F.; Ramsden, J.J.; Gupta, R.K. Extended In Vitro Inactivation of SARS-CoV-2 by Titanium Dioxide Surface Coating. bioRxiv 2020, 1–10. [Google Scholar] [CrossRef]
- Assis, M.; Simoes, L.G.P.; Tremiliosi, G.C.; Coelho, D.; Minozzi, D.T.; Santos, R.I.; Vilela, D.C.B.; do Santos, J.R.; Ribeiro, L.K.; Rosa, I.L.V.; et al. SiO2-Ag Composite as a Highly Virucidal Material: A Roadmap That Rapidly Eliminates SARS-CoV-2. Nanomaterials 2021, 11, 638. [Google Scholar] [CrossRef]
- Hosseini, M.; Behzadinasab, S.; Chin, A.W.H.; Poon, L.L.M.; Ducker, W.A. Reduction of Infectivity of SARS-CoV-2 by Zinc Oxide Coatings. ACS Biomater. Sci. Eng. 2021, 7, 5022–5027. [Google Scholar] [CrossRef]
- Mantlo, E.K.; Paessler, S.; Seregin, A.; Mitchell, A. Luminore CopperTouch Surface Coating Effectively Inactivates SARS-CoV-2, Ebola Virus, and Marburg Virus in Vitro. Antimicrob. Agents Chemother. 2021, 65, e01390-20. [Google Scholar] [CrossRef]
- Hewawaduge, C.; Senevirathne, A.; Jawalagatti, V.; Kim, J.W.; Lee, J.H. Copper-Impregnated Three-Layer Mask Efficiently Inactivates SARS-CoV-2. Environ. Res. 2021, 196, 110947. [Google Scholar] [CrossRef] [PubMed]
- Hosseini, M.; Chin, A.W.H.; Behzadinasab, S.; Poon, L.L.M.; Ducker, W.A. Cupric Oxide Coating That Rapidly Reduces Infection by SARS-CoV-2 via Solids. ACS Appl. Mater. Interfaces 2021, 13, 5919–5928. [Google Scholar] [CrossRef] [PubMed]
- Warnes, S.L.; Keevil, C.W. Inactivation of Norovirus on Dry Copper Alloy Surfaces. PLoS ONE 2013, 8, e75017. [Google Scholar] [CrossRef] [Green Version]
- Ettayebi, K.; Tenge, V.R.; Cortes-Penfield, N.W.; Crawford, S.E.; Neill, F.H.; Zeng, X.-L.; Yu, X.; Ayyar, B.V.; Burrin, D.; Ramani, S.; et al. New Insights and Enhanced Human Norovirus Cultivation in Human Intestinal Enteroids. mSphere 2021, 6, e01136-20. [Google Scholar] [CrossRef] [PubMed]
- Hirneisen, K.A.; Kniel, K.E. Comparing Human Norovirus Surrogates: Murine Norovirus and Tulane Virus. J. Food Prot. 2013, 76, 139–143. [Google Scholar] [CrossRef]
- Hierholzer, J.C.; Killington, R.A. Virus Isolation and Quantitation. Virol. Methods Man. 1996, 25–46. [Google Scholar] [CrossRef]
- Corman, V.M.; Landt, O.; Kaiser, M.; Molenkamp, R.; Meijer, A.; Chu, D.K.W.; Bleicker, T.; Brünink, S.; Schneider, J.; Schmidt, M.L.; et al. Detection of 2019 Novel Coronavirus (2019-NCoV) by Real-Time RT-PCR. Eurosurveillance 2020, 25, 2000045. [Google Scholar] [CrossRef] [Green Version]
- Mosselhy, D.A.; Kareinen, L.; Kivistö, I.; Aaltonen, K.; Virtanen, J.; Ge, Y.; Sironen, T. Copper-Silver Nanohybrids : SARS-CoV-2 Inhibitory Surfaces. Nanomaterials 2021, 11, 1820. [Google Scholar] [CrossRef]
- van Doremalen, N.; Bushmaker, T.; Morris, D.H.; Holbrook, M.G.; Gamble, A.; Williamson, B.N.; Tamin, A.; Harcourt, J.L.; Thornburg, N.J.; Gerber, S.I.; et al. Aerosol and Surface Stability of SARS-CoV-2 as Compared with SARS-CoV-1. N. Engl. J. Med. 2020, 382, 1564–1567. [Google Scholar] [CrossRef]
- Chin, A.W.H.; Chu, J.T.S.; Perera, M.R.A.; Hui, K.P.Y.; Yen, H.-L.; Chan, M.C.W.; Peiris, M.; Poon, L.L.M. Stability of SARS-CoV-2 in Different Environmental Conditions. Lancet Microbe 2020, 1, e10. [Google Scholar] [CrossRef]
- Liu, Y.; Li, T.; Deng, Y.; Liu, S.; Zhang, D.; Li, H.; Wang, X.; Jia, L.; Han, J.; Bei, Z.; et al. Stability of SARS-CoV-2 on Environmental Surfaces and in Human Excreta. J. Hosp. Infect. 2021, 107, 105–107. [Google Scholar] [CrossRef] [PubMed]
- Bonil, L.; Lingas, G.; Coupeau, D.; Lucet, J.C.; Guedj, J.; Visseaux, B.; Muylkens, B. Survival of SARS-CoV-2 on Non-Porous Materials in an Experimental Setting Representative of Fomites. Coatings 2021, 11, 371. [Google Scholar] [CrossRef]
- Robilotti, E.; Deresinski, S.; Pinsky, B.A. Norovirus. Clin. Microbiol. Rev. 2015, 28, 134–164. [Google Scholar] [CrossRef] [PubMed] [Green Version]
- Mosselhy, D.A.; Virtanen, J.; Kant, R.; He, W.; Elbahri, M.; Sironen, T. COVID-19 Pandemic: What about the Safety of Anti-Coronavirus Nanoparticles? Nanomaterials 2021, 11, 796. [Google Scholar] [CrossRef] [PubMed]
- Mosselhy, D.A.; Granbohm, H.; Hynönen, U.; Ge, Y.; Palva, A.; Nordström, K.; Hannula, S.-P. Nanosilver–Silica Composite: Prolonged Antibacterial Effects and Bacterial Interaction Mechanisms for Wound Dressings. Nanomaterials 2017, 7, 261. [Google Scholar] [CrossRef]
- Bezza, F.A.; Tichapondwa, S.M.; Chirwa, E.M.N. Fabrication of Monodispersed Copper Oxide Nanoparticles with Potential Application as Antimicrobial Agents. Sci. Rep. 2020, 10, 16680. [Google Scholar] [CrossRef]
- Mosselhy, D.A.; Assad, M.; Sironen, T.; Elbahri, M. Nanotheranostics: A Possible Solution for Drug-Resistant Staphylococcus aureus and Their Biofilms? Nanomaterials 2021, 11, 82. [Google Scholar] [CrossRef]

Publisher’s Note: MDPI stays neutral with regard to jurisdictional claims in published maps and institutional affiliations. |
© 2022 by the authors. Licensee MDPI, Basel, Switzerland. This article is an open access article distributed under the terms and conditions of the Creative Commons Attribution (CC BY) license (https://creativecommons.org/licenses/by/4.0/).
Share and Cite
Mosselhy, D.A.; Kareinen, L.; Kivistö, I.; Virtanen, J.; Loikkanen, E.; Ge, Y.; Maunula, L.; Sironen, T. Inhibition of SARS-CoV-2 Alpha Variant and Murine Noroviruses on Copper-Silver Nanocomposite Surfaces. Nanomaterials 2022, 12, 1037. https://doi.org/10.3390/nano12071037
Mosselhy DA, Kareinen L, Kivistö I, Virtanen J, Loikkanen E, Ge Y, Maunula L, Sironen T. Inhibition of SARS-CoV-2 Alpha Variant and Murine Noroviruses on Copper-Silver Nanocomposite Surfaces. Nanomaterials. 2022; 12(7):1037. https://doi.org/10.3390/nano12071037
Chicago/Turabian StyleMosselhy, Dina A., Lauri Kareinen, Ilkka Kivistö, Jenni Virtanen, Emil Loikkanen, Yanling Ge, Leena Maunula, and Tarja Sironen. 2022. "Inhibition of SARS-CoV-2 Alpha Variant and Murine Noroviruses on Copper-Silver Nanocomposite Surfaces" Nanomaterials 12, no. 7: 1037. https://doi.org/10.3390/nano12071037
APA StyleMosselhy, D. A., Kareinen, L., Kivistö, I., Virtanen, J., Loikkanen, E., Ge, Y., Maunula, L., & Sironen, T. (2022). Inhibition of SARS-CoV-2 Alpha Variant and Murine Noroviruses on Copper-Silver Nanocomposite Surfaces. Nanomaterials, 12(7), 1037. https://doi.org/10.3390/nano12071037

